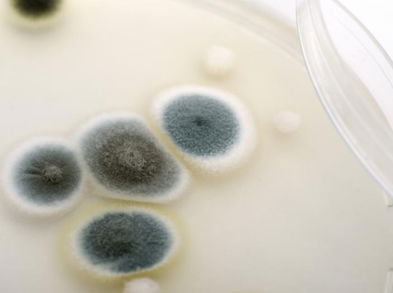
¿Qué alimentos con moho hay que desechar y cuáles se pueden comer?

-
![Beneficios de la fangoterapia para la salud]()
Beneficios de la fangoterapia para la salud
Siempre hemos asociado el fango con una forma de cuidar la piel, dejando un efecto suave y tonificado. Pero se trata de un medio n
-
![Elimina las toxinas con estas bebidas naturales]()
Elimina las toxinas con estas bebidas naturales
Como es sabido, el agua es uno de los mejores depurativos para el organismo, ya que estimula la digestión, favorece la eliminación
-
![4 alimentos para desintoxicarte después del atracón de nochevieja]()
4 alimentos para desintoxicarte después del atracón de nochevieja
Ahora que ha comenzado el 2020, estoy segura de que habrás comido y bebido mucho más que lo habitual. Después de todos esos atraco
-
![Desintoxica las axilas para prevenir infecciones]()
Desintoxica las axilas para prevenir infecciones
Seguramente llevas un par de años usando desodorantes para reducir el olor de la transpiración. Las glándulas sudoríparas facilita
-
![Dieta de sirope de arce para eliminar toxinas]()
Dieta de sirope de arce para eliminar toxinas
La dieta del sirope de arce es un tratamiento que ayuda a depurar el organismo en unos cuantos días, eliminando las toxinas, impur
-
![¿Qué alimentos con moho hay que desechar y cuáles se pueden comer?]()
¿Qué alimentos con moho hay que desechar y cuáles se pueden comer?
El moho es un hongo que por lo regular crece con mayor rapidez en condiciones húmedas y cálidas. Así que existe la presencia de al
-
![Posturas Yoga para decirle adiós a las toxinas]()
Posturas Yoga para decirle adiós a las toxinas
El comer de manera saludable va a ayudar a que el organismo trabaje de manera correcta. Sin embargo, los excesos culposos a veces
-
![Deshazte de las toxinas con estas deliciosas frutas]()
Deshazte de las toxinas con estas deliciosas frutas
Las toxinas acumuladas pueden llegar a afectar el organismo. Estas se pueden encontrar en cualquier lugar como los alimentos, el a
-
![¿Deseas bajar de peso? Los masajes pueden ser una buena opción]()
¿Deseas bajar de peso? Los masajes pueden ser una buena opción
Has intentado cuidar tu cuerpo con dietas y ejercicios y, quizás te funciona a la perfección. Pero ¿deseas bajar un poco más de pe
-
![¿Qué alimentos acumulan más toxinas?]()
¿Qué alimentos acumulan más toxinas?
Las toxinas se encuentran en la mayoría de alimentos y, esto se debe, a los tóxicos naturales o químicos con los que cuentan. Dich
-
![Dile adiós a las toxinas con estos 3 ejercicios]()
Dile adiós a las toxinas con estos 3 ejercicios
Eliminar las toxinas del cuerpo es importante para bajar de peso, evitar la celulitis pero, sobre todo, para mantener un buen esta
-
![¿Qué es la Chlorella y cuáles son sus beneficios?]()
¿Qué es la Chlorella y cuáles son sus beneficios?
A diario acumulamos toxinas, ya sea por nuestra alimentación, por el agua que bebemos o por el aire que respiramos, entre otras co
-
![Desintoxícate y baja de peso con 3 consejos naturales]()
Desintoxícate y baja de peso con 3 consejos naturales
Cuando nuestra dieta es poco equilibrada o simplemente llevamos malos hábitos como tomar bebidas alcohólicas, dormir poco o fumar,
-
![Sudar y adelgazar son dos conceptos que no van de la mano]()
Sudar y adelgazar son dos conceptos que no van de la mano
Tenemos la 'sana' costumbre de pensar que cuando sudamos estamos perdiendo grasa y adelgazamos. Esto no es cierto chicos y chicas,